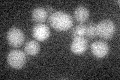
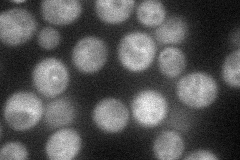
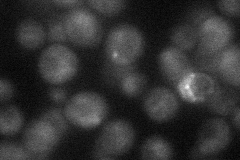
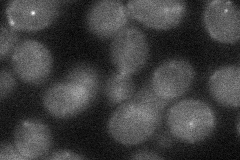

View description
PIK-related protein kinase and rapamycin target; subunit of TORC1, a complex that controls growth in response to nutrients by regulating translation, transcription, ribosome biogenesis, nutrient transport and autophagy; involved in meiosis
Localization:
Intensity:
Fold change:
Significance:
-
C’ GFP library in SD
below threshold14.18 -
N' NOP1pr-GFP in SD
cytosol,punctate,vacuole membrane48.3635 -
N' TEF2pr-mCherry in SD
punctate,vacuole membrane22.3735 -
N' NATIVEpr-GFP in SD

below threshold15.2467 -
N' TEF2pr-VC and Cyto-VN in SD
below threshold27.9893 -
C’ GFP library in SD+DTT

cytosol13.750.96No -
C’ GFP library in SD+H2O2

cytosol15.241.07No -
C’ GFP library in Starvation Media

cytosol16.221.14No -
C’ GFP library on the background of Pup2-DaMP

below threshold -
C’ GFP library on the background of CCT mutant

below threshold13.77990.971619No
